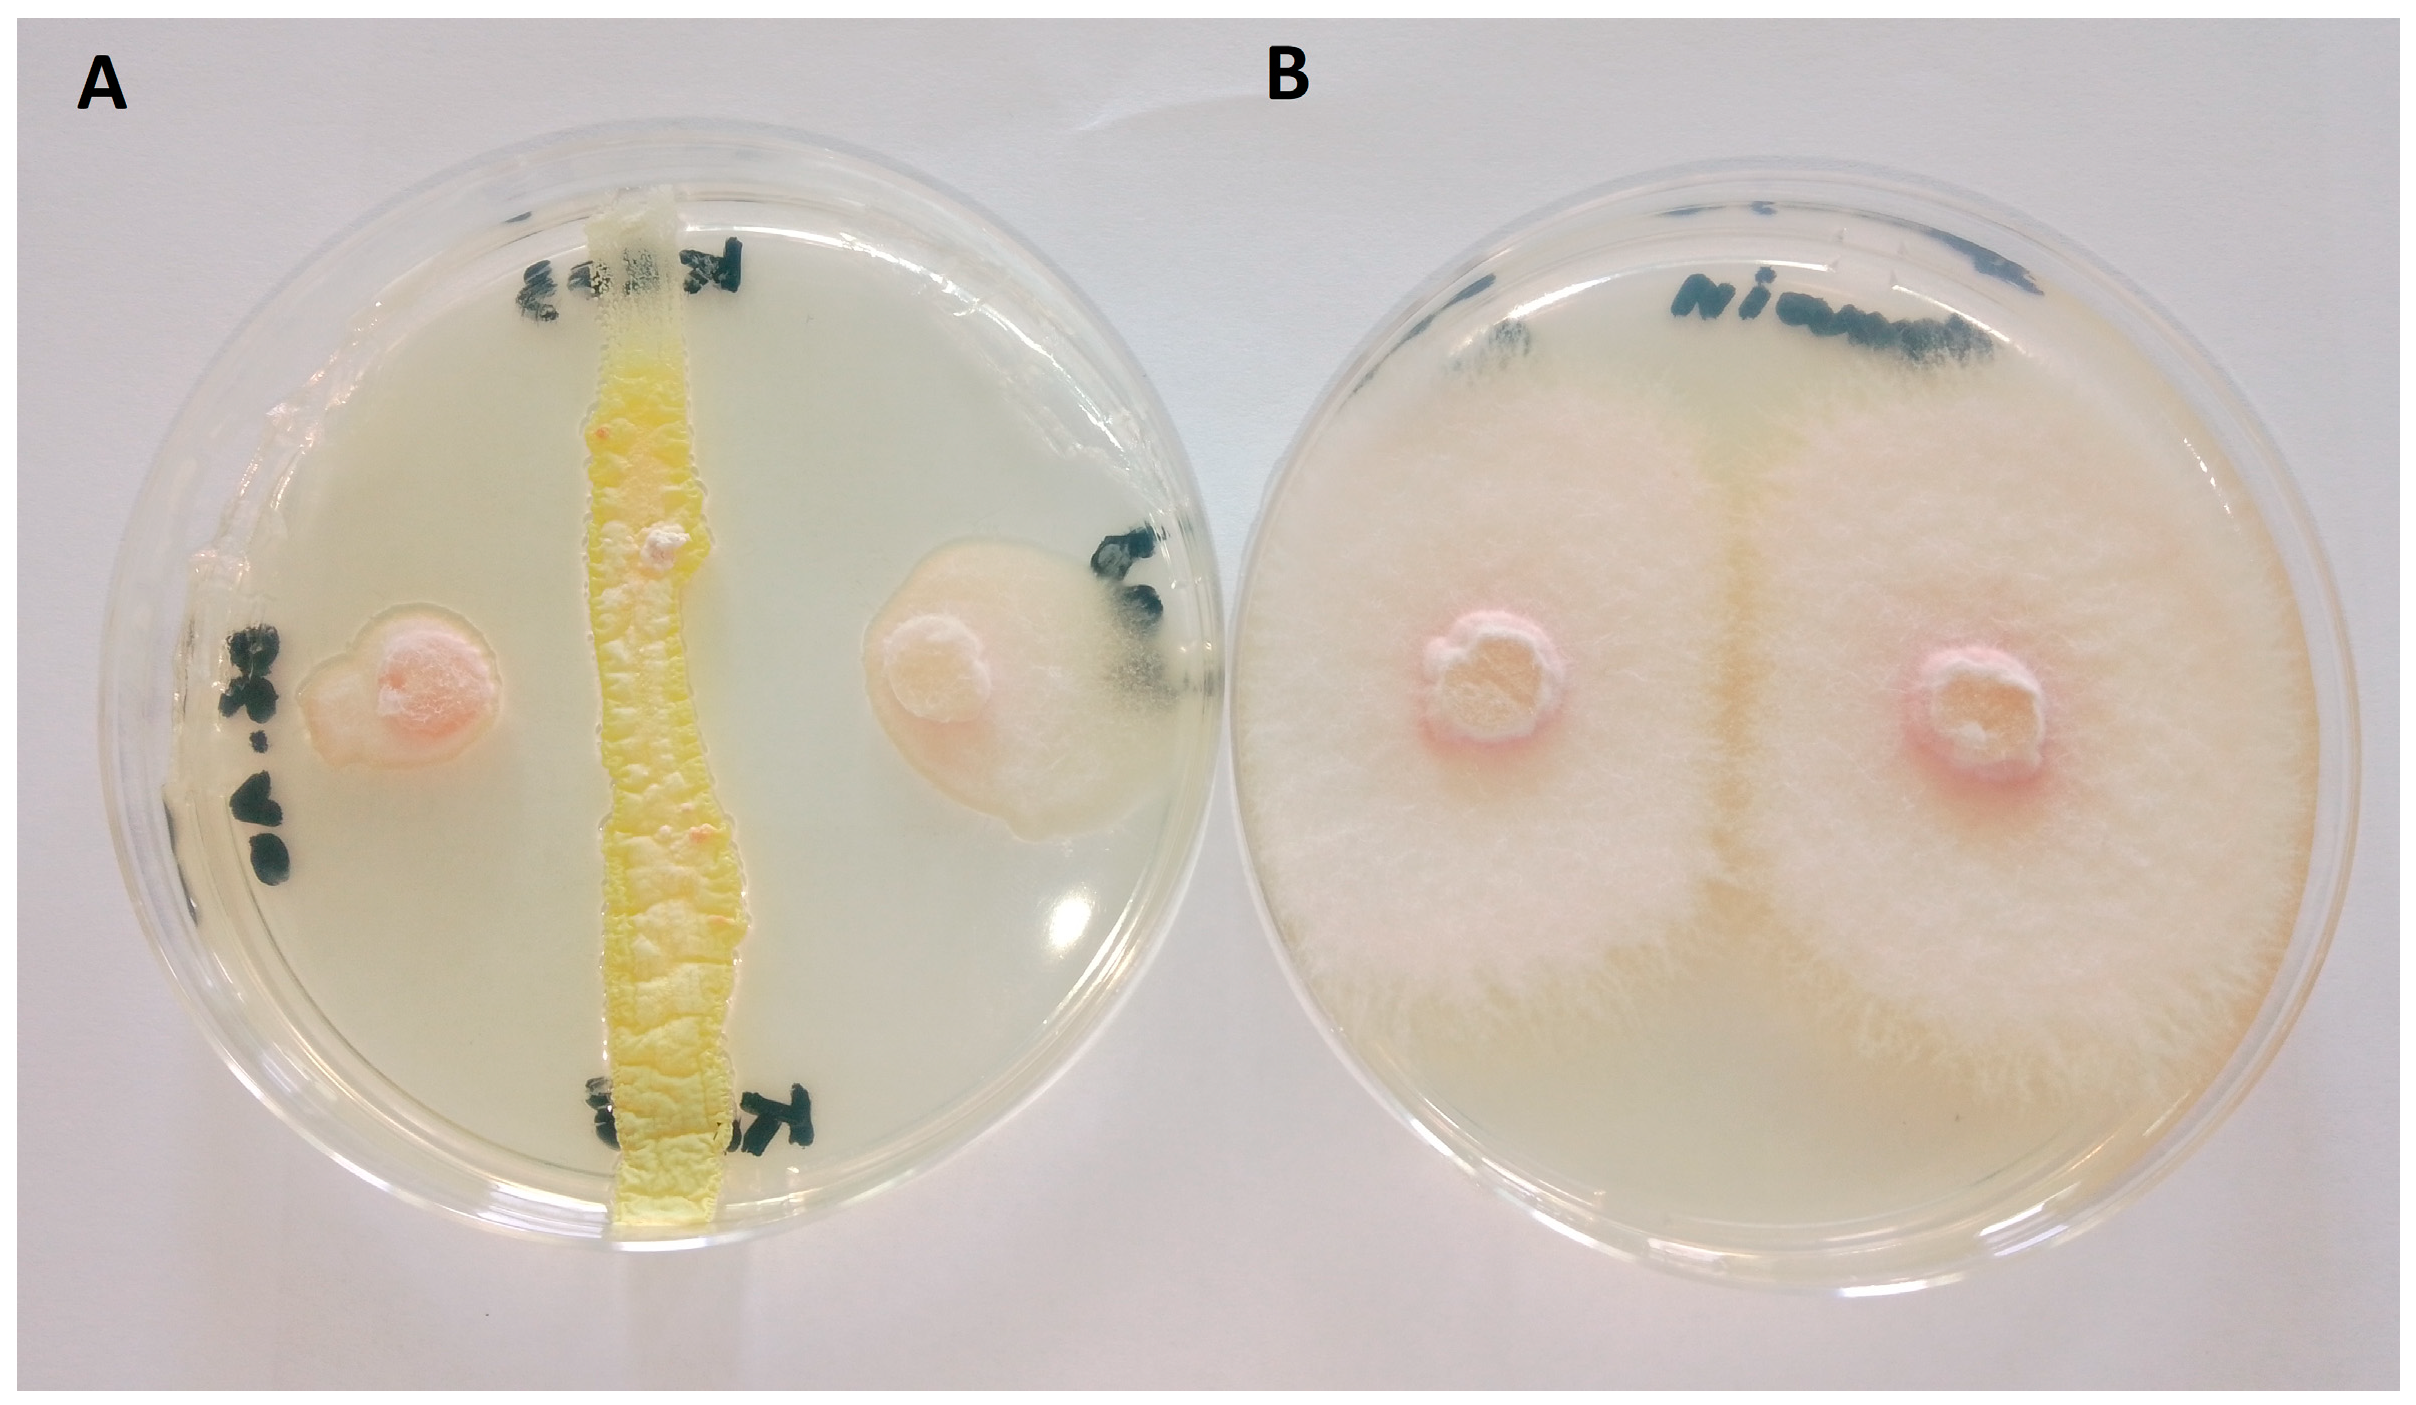
Jof 10 00783 g001

An Algerian Soil-Living Streptomyces alboflavus Strain as Source of Antifungal Compounds for the Management of the Pea Pathogen Fusarium oxysporum f. sp. pisi
Abstract
1. Introduction
2. Materials and Methods
2.1. General Experimental Procedures
2.2. Microorganism and Culture Conditions
2.3. In Vitro Antifungal Activity of the Strain
2.4. Bacterial Growth and Extraction of Bioactive Compounds
2.5. Antifungal Activity of the Organic Extract, Chromatographic Fractions (FA-FE), and Metacycloprodigiosin
2.6. Isolation of Bacterial Metabolites
2.7. GC-MS Analysis of Fractions FB-FE
2.8. Statistical Analysis
3. Results
3.1. The Strain KRO3
3.2. In Vitro Antifungal Activity of the Strain
3.3. Antifungal Activity of the Organic Extract
3.4. Fractionation of the Organic Extract and Evaluation of the Antifungal Activity
3.5. Purification of Fraction FA
3.6. Antifungal Activity of Metacycloprodigiosin
3.7. Identification of Metabolites in Fractions FB-FE
4. Discussion
Supplementary Materials
Author Contributions
Funding
Institutional Review Board Statement
Informed Consent Statement
Data Availability Statement
Acknowledgments
Conflicts of Interest
References
- Rubiales, D.; Fondevilla, S.; Chen, W.; Gentzbittel, L.; Higgins, T.J.V.; Castillejo, M.A.; Singh, K.B.; Rispail, N. Achievements and Challenges in Legume Breeding for Pest and Disease Resistance. CRC Crit. Rev. Plant Sci. 2015, 34, 195–236. [Google Scholar] [CrossRef]
- Purohit, A.; Ghosh, S.; Chaudhuri, R.K.; Chakraborti, D. Biological Control of Fusarium Wilt in Legumes. In Plant Stress Mitigators; Elsevier: Amsterdam, The Netherlands, 2023; pp. 435–454. [Google Scholar]
- Lal, D.; Dev, D.; Kumari, S.; Pandey, S.; Aparna; Sharma, N.; Nandni, S.; Jha, R.K.; Singh, A. Fusarium Wilt Pandemic: Current Understanding and Molecular Perspectives. Funct. Integr. Genom. 2024, 24, 41. [Google Scholar] [CrossRef]
- Aslam, S.; Ghazanfar, M.U.; Munir, N.; Hamid, M.I. Managing Fusarium Wilt of Pea by Utilizing Different Application Methods of Fungicides. Pak. J. Phytopathol. 2019, 31, 81–88. [Google Scholar] [CrossRef]
- Bani, M.; Rubiales, D.; Rispail, N. A Detailed Evaluation Method to Identify Sources of Quantitative Resistance to Fusarium Oxysporum f. sp. Pisi Race 2 within a Pisum spp. Germplasm Collection. Plant Pathol. 2012, 61, 532–542. [Google Scholar] [CrossRef]
- Navas-Cortés, J.A.; Hau, B.; Jiménez-Díaz, R.M. Effect of Sowing Date, Host Cultivar, and Race of Fusarium Oxysporum f. sp. Ciceris on Development of Fusarium Wilt of Chickpea. Phytopathology 1998, 88, 1338–1346. [Google Scholar] [CrossRef]
- Momma, N.; Momma, M.; Kobara, Y. Biological Soil Disinfestation Using Ethanol: Effect on Fusarium Oxysporum f. sp. Lycopersici and Soil Microorganisms. J. Gen. Plant Pathol. 2010, 76, 336–344. [Google Scholar] [CrossRef]
- Chen, Y.; Zhou, D.; Qi, D.; Gao, Z.; Xie, J.; Luo, Y. Growth Promotion and Disease Suppression Ability of a Streptomyces sp. CB-75 from Banana Rhizosphere Soil. Front. Microbiol. 2018, 8, 2704. [Google Scholar] [CrossRef]
- Torres-Rodriguez, J.A.; Reyes-Pérez, J.J.; Quiñones-Aguilar, E.E.; Hernandez-Montiel, L.G. Actinomycete Potential as Biocontrol Agent of Phytopathogenic Fungi: Mechanisms, Source, and Applications. Plants 2022, 11, 3201. [Google Scholar] [CrossRef]
- Jose, P.A.; Maharshi, A.; Jha, B. Actinobacteria in Natural Products Research: Progress and Prospects. Microbiol. Res. 2021, 246, 126708. [Google Scholar] [CrossRef]
- Yun, T.Y.; Feng, R.J.; Zhou, D.B.; Pan, Y.Y.; Chen, Y.F.; Wang, F.; Yin, L.Y.; Zhang, Y.D.; Xie, J.H. Optimization of Fermentation Conditions through Response Surface Methodology for Enhanced Antibacterial Metabolite Production by Streptomyces sp. 1–14 from Cassava Rhizosphere. PLoS ONE 2018, 13, e0206497. [Google Scholar] [CrossRef]
- Sharma, M.; Manhas, R.K. Purification and Characterization of Salvianolic Acid B from Streptomyces sp. M4 Possessing Antifungal Activity against Fungal Phytopathogens. Microbiol. Res. 2020, 237, 126478. [Google Scholar] [CrossRef] [PubMed]
- Wei, Y.; Zhao, Y.; Zhou, D.; Qi, D.; Li, K.; Tang, W.; Chen, Y.; Jing, T.; Zang, X.; Xie, J.; et al. A Newly Isolated Streptomyces sp. YYS-7 with a Broad-Spectrum Antifungal Activity Improves the Banana Plant Resistance to Fusarium Oxysporum f. sp. Cubense Tropical Race 4. Front. Microbiol. 2020, 11, 1712. [Google Scholar] [CrossRef] [PubMed]
- Aggarwal, N.; Thind, S.K.; Sharma, S. Role of Secondary Metabolites of Actinomycetes in Crop Protection. In Plant Growth Promoting Actinobacteria; Springer: Singapore, 2016; pp. 99–121. [Google Scholar]
- Girão, M.; Ribeiro, I.; Ribeiro, T.; Azevedo, I.C.; Pereira, F.; Urbatzka, R.; Leão, P.N.; Carvalho, M.F. Actinobacteria Isolated From Laminaria ochroleuca: A Source of New Bioactive Compounds. Front. Microbiol. 2019, 10, 428916. [Google Scholar] [CrossRef]
- Khenaka, K.; Loredana, C.; Benedetti, A.; Leulmi, N.; Boulahrouf, A. Effect of Capsicum annuum cultivated in sub-alkaline soil on bacterial community and activities of cultivable plant growth promoting bacteria under field conditions. Arch. Agron. Soil Sci. 2019, 65, 1417–1430. [Google Scholar] [CrossRef]
- Liu, D.; Coloe, S.; Baird, R.; Pedersen, J. Rapid Mini-Preparation of Fungal DNA for PCR. J. Clin. Microbiol. 2000, 38, 471. [Google Scholar] [CrossRef]
- Castaldi, S.; Zorrilla, J.G.; Petrillo, C.; Russo, M.T.; Ambrosino, P.; Masi, M.; Cimmino, A.; Isticato, R. Alternaria alternata Isolated from Infected Pears (Pyrus communis) in Italy Produces Non-Host Toxins and Hydrolytic Enzymes as Infection Mechanisms and Exhibits Competitive Exclusion against Botrytis cinerea in Co-Infected Host Fruits. J. Fungi 2023, 9, 326. [Google Scholar] [CrossRef]
- Lane, D. 16S/23S RRNA Sequencing. In Nucleic Acid Techniques in Bacterial Systematics; Stackebrandt, E., Goodfellow, M., Eds.; John Wiley and Sons: Chichester, UK, 1991; pp. 115–175. [Google Scholar]
- Yoon, S.-H.; Ha, S.-M.; Kwon, S.; Lim, J.; Kim, Y.; Seo, H.; Chun, J. Introducing EzBioCloud: A Taxonomically United Database of 16S RRNA Gene Sequences and Whole-Genome Assemblies. Int. J. Syst. Evol. Microbiol. 2017, 67, 1613–1617. [Google Scholar] [CrossRef] [PubMed]
- Bani, M.; Rispail, N.; Evidente, A.; Rubiales, D.; Cimmino, A. Identification of the Main Toxins Isolated from Fusarium oxysporum f. Sp. Pisi Race 2 and Their Relation with Isolates’ Pathogenicity. J. Agric. Food Chem. 2014, 62, 2574–2580. [Google Scholar] [CrossRef] [PubMed]
- Zdorovenko, E.L.; Dmitrenok, A.S.; Masi, M.; Castaldi, S.; Muzio, F.M.; Isticato, R.; Valverde, C.; Knirel, Y.A.; Evidente, A. Structural Studies on the O-Specific Polysaccharide of the Lipopolysaccharide from Pseudomonas donghuensis Strain SVBP6, with Antifungal Activity against the Phytopathogenic Fungus Macrophomina phaseolina. Int. J. Biol. Macromol. 2021, 182, 2019–2023. [Google Scholar] [CrossRef]
- Leulmi, N.; Sighel, D.; Defant, A.; Khenaka, K.; Boulahrouf, A.; Mancini, I. Nigericin and Grisorixin Methyl Ester from the Algerian Soil-Living Streptomyces youssoufiensis SF10 Strain: A Computational Study on Their Epimeric Structures and Evaluation of Glioblastoma Stem Cells Growth Inhibition. Nat. Prod. Res. 2019, 33, 266–273. [Google Scholar] [CrossRef]
- Masi, M.; Castaldi, S.; Sautua, F.; Pescitelli, G.; Carmona, M.A.; Evidente, A. Truncatenolide, a Bioactive Disubstituted Nonenolide Produced by Colletotrichum truncatum, the Causal Agent of Anthracnose of Soybean in Argentina: Fungal Antagonism and SAR Studies. J. Agric. Food Chem. 2022, 70, 9834–9844. [Google Scholar] [CrossRef] [PubMed]
- Wasserman, H.H.; Keith, D.D.; Rodgers, G.C. The Structure of Metacycloprodigiosin. Tetrahedron 1976, 32, 1855–1861. [Google Scholar] [CrossRef]
- Guida, M.; Salvatore, M.M.; Salvatore, F. A Strategy for GC/MS Quantification of Polar Compounds via Their Silylated Surrogates: Silylation and Quantification of Biological Amino Acids. J. Anal. Bioanal. Tech. 2015, 6, 1–16. [Google Scholar] [CrossRef]
- Kimata, S.; Izawa, M.; Kawasaki, T.; Hayakawa, Y. Identification of a Prodigiosin Cyclization Gene in the Roseophilin Producer and Production of a New Cyclized Prodigiosin in a Heterologous Host. J. Antibiot. 2017, 70, 196–199. [Google Scholar] [CrossRef]
- Hu, D.X.; Withall, D.M.; Challis, G.L.; Thomson, R.J. Structure, Chemical Synthesis, and Biosynthesis of Prodiginine Natural Products. Chem. Rev. 2016, 116, 7818–7853. [Google Scholar] [CrossRef] [PubMed]
- Yang, H.; Li, Y.; Jiang, M.; Wang, J.; Fu, H. General Copper-Catalyzed Transformations of Functional Groups from Arylboronic Acids in Water. Chem.–A Eur. J. 2011, 17, 5652–5660. [Google Scholar] [CrossRef]
- De, S.; Kumar, T.; Bohre, A.; Singh, L.R.; Saha, B. Furan-Based Acetylating Agent for the Chemical Modification of Proteins. Bioorg. Med. Chem. 2015, 23, 791–796. [Google Scholar] [CrossRef]
- Qi, D.; Zou, L.; Zhou, D.; Zhang, M.; Wei, Y.; Zhang, L.; Xie, J.; Wang, W. Identification and Antifungal Mechanism of a Novel Actinobacterium Streptomyces huiliensis sp. Nov. Against Fusarium oxysporum f. sp. Cubense Tropical Race 4 of Banana. Front. Microbiol. 2021, 12, 722661. [Google Scholar] [CrossRef]
- Abbasi, S.; Safaie, N.; Sadeghi, A.; Shamsbakhsh, M. Streptomyces Strains Induce Resistance to Fusarium oxysporum f. sp. Lycopersici Race 3 in Tomato Through Different Molecular Mechanisms. Front. Microbiol. 2019, 10, 1505. [Google Scholar] [CrossRef]
- Pengproh, R.; Thanyasiriwat, T.; Sangdee, K.; Kawicha, P.; Sangdee, A. Antagonistic Ability and Genome Mining of Soil Streptomyces spp. against Fusarium oxysporum f. sp. Lycopersici. Eur. J. Plant Pathol. 2023, 167, 251–270. [Google Scholar] [CrossRef]
- Amini, J.; Agapoor, Z.; Ashengroph, M. Evaluation of Streptomyces spp. against Fusarium oxysporum f. sp. Ciceris for the Management of Chickpea Wilt. J. Plant Prot. Res. 2016, 56, 257–264. [Google Scholar] [CrossRef]
- Wasserman, H.H.; Rodgers, G.C.; Keith, D.D. Metacycloprodigiosin, a Tripyrrole Pigment from Streptomyces longisporus Ruber. J. Am. Chem. Soc. 1969, 91, 1263–1264. [Google Scholar] [CrossRef] [PubMed]
- De Carvalho, C.; Caramujo, M. The Various Roles of Fatty Acids. Molecules 2018, 23, 2583. [Google Scholar] [CrossRef]
- Ilic-Tomic, T.; Genčić, M.S.; Živković, M.Z.; Vasiljevic, B.; Djokic, L.; Nikodinovic-Runic, J.; Radulović, N.S. Structural Diversity and Possible Functional Roles of Free Fatty Acids of the Novel Soil Isolate Streptomyces sp. NP10. Appl. Microbiol. Biotechnol. 2015, 99, 4815–4833. [Google Scholar] [CrossRef] [PubMed]
- Donald, L.; Pipite, A.; Subramani, R.; Owen, J.; Keyzers, R.A.; Taufa, T. Streptomyces: Still the Biggest Producer of New Natural Secondary Metabolites, a Current Perspective. Microbiol. Res. 2022, 13, 418–465. [Google Scholar] [CrossRef]
- Kuo, Y.-Y.; Li, S.-Y. Solid-State Fermentation of Food Waste by Serratia marcescens NCHU05 for Prodigiosin Production. J. Taiwan Inst. Chem. Eng. 2024, 160, 105260. [Google Scholar] [CrossRef]
- Paul, T.; Mondal, A.; Bandyopadhyay, T.K.; Mahata, N.; Bhunia, B. Downstream Process Development for Extraction of Prodigiosin: Statistical Optimization, Kinetics, and Biochemical Characterization. Appl. Biochem. Biotechnol. 2022, 194, 5403–5418. [Google Scholar] [CrossRef]
- Wasserman, H.H.; Rodgers, G.C.; Keith, D.D. The Structure and Synthesis of Undecylprodigiosin. A Prodigiosin Analogue from Streptomyces. Chem. Commun. 1966, 22, 825–826. [Google Scholar] [CrossRef]
- Clift, M.D.; Thomson, R.J. Development of a Merged Conjugate Addition/Oxidative Coupling Sequence. Application to the Enantioselective Total Synthesis of Metacycloprodigiosin and Prodigiosin R1. J. Am. Chem. Soc. 2009, 131, 14579–14583. [Google Scholar] [CrossRef]
- Hu, D.X.; Clift, M.D.; Lazarski, K.E.; Thomson, R.J. Enantioselective Total Synthesis and Confirmation of the Absolute and Relative Stereochemistry of Streptorubin B. J. Am. Chem. Soc. 2011, 133, 1799–1804. [Google Scholar] [CrossRef]
- Peixoto, D.; Ferreira, E.P.; Lourenço, A.M.; Johnson, J.L.; Lobo, A.M.; Polavarapu, P.L. (R)-Metacycloprodigiosin-HCl: Chiroptical Properties and Structure. Chirality 2018, 30, 932–942. [Google Scholar] [CrossRef] [PubMed]
- Srilekha, V.; Krishna, G.; Sreelatha, B.; Jagadeesh Kumar, E.; Rajeshwari, K.V.N. Prodigiosin: A Fascinating and the Most Versatile Bioactive Pigment with Diverse Applications. Syst. Microbiol. Biomanufacturing 2024, 4, 66–76. [Google Scholar] [CrossRef]
- Islan, G.A.; Rodenak-Kladniew, B.; Noacco, N.; Duran, N.; Castro, G.R. Prodigiosin: A Promising Biomolecule with Many Potential Biomedical Applications. Bioengineered 2022, 13, 14227–14258. [Google Scholar] [CrossRef]
- Someya, N.; Nakajima, M.; Hirayae, K.; Hibi, T.; Akutsu, K. Synergistic Antifungal Activity of Chitinolytic Enzymes and Prodigiosin Produced by Biocontrol Bacterium, Serratia marcescens Strain B2 against Gray Mold Pathogen, Botrytis cinerea. J. Gen. Plant Pathol. 2001, 67, 312–317. [Google Scholar] [CrossRef]
- Rahul, S.; Chandrashekhar, P.; Hemant, B.; Chandrakant, N.; Laxmikant, S.; Satish, P. Nematicidal Activity of Microbial Pigment from Serratia Marcescens. Nat. Prod. Res. 2014, 28, 1399–1404. [Google Scholar] [CrossRef] [PubMed]
- Habash, S.S.; Brass, H.U.C.; Klein, A.S.; Klebl, D.P.; Weber, T.M.; Classen, T.; Pietruszka, J.; Grundler, F.M.W.; Schleker, A.S.S. Novel Prodiginine Derivatives Demonstrate Bioactivities on Plants, Nematodes, and Fungi. Front. Plant Sci. 2020, 11, 579807. [Google Scholar] [CrossRef]
- Araújo, R.G.; Zavala, N.R.; Castillo-Zacarías, C.; Barocio, M.E.; Hidalgo-Vázquez, E.; Parra-Arroyo, L.; Rodríguez-Hernández, J.A.; Martínez-Prado, M.A.; Sosa-Hernández, J.E.; Martínez-Ruiz, M.; et al. Recent Advances in Prodigiosin as a Bioactive Compound in Nanocomposite Applications. Molecules 2022, 27, 4982. [Google Scholar] [CrossRef]

| Carbon Source Utilization | Nitrogen Source Utilization | Growth in the Presence of. . . | Degradation Activity |
|---|---|---|---|
| Arabinose + | Histidine + | pH 4 − | Gelatin + |
| Fructose + | Arginine + | pH 7 + | Casein + |
| Galactose + | Tyrosine + | pH 9 + | Starch − |
| Inositol + | Alanine + | NaCl 6% w/v + | Cellulose − |
| Mannitol + | Glycine + | NaCl 8% w/v + | |
| Glucose + | Methionine + | NaCl 8% w/v + | |
| Lactose + | Valine + | Phenol 0.1% w/v + | |
| Rhamnose − | Leucine + | Penicillin 10 UI + | |
| Maltose + | Tryptophan + | Growth at 45 °C + | |
| Sucrose + | Asparagine + | Nitrate reduction + | |
| Sorbitol + | Proline + | ||
| Xylitol + | |||
| Mannose + | |||
| Xylose − |
| Compound | RT (min) | RI | Peak Area% |
|---|---|---|---|
| Fraction FB | |||
| Myristic acid, TMS | 12.59 | 1814 | 6.88 |
| Pentadecanoic acid, TMS | 13.04 | 1915 | 45.46 |
| Palmitelaidic acid, TMS | 13.36 | 1994 | 2.65 |
| Palmitic acid, TMS | 13.42 | 2011 | 23.01 |
| Margaric acid, TMS | 13.81 | 2118 | 13.03 |
| 10-Heptadecenoic acid, TMS | 13.87 | 2137 | 8.69 |
| Oleic acid, TMS | 14.07 | 2192 | 0.28 |
| Fraction FC | |||
| 4-Nitrobenzamide, TMS | 12.82 | 1864 | - |
| Fraction FD | |||
| 1-Monomyrisitin, 2TMS | 14.72 | 2362 | 1.14 |
| 2-Monopalmitin, 2TMS | 14.98 | 2423 | 0.21 |
| Pentadecanoic acid, glycerine-(1)-monoester, 2TMS | 15.16 | 2461 | 25.88 |
| 1-Monopalmitin, 2TMS | 15.66 | 2559 | 36.28 |
| Heptadecanoic acid, glycerine-(1)-monoester, 2TMS | 16.25 | 2652 | 29.86 |
| 1-Monooleoylglycerol, 2TMS | 16.90 | 2746 | 6.64 |
| Fraction FE | |||
| Furandimethanol (2TMS) | 9.54 | 1427 | - |
Disclaimer/Publisher’s Note: The statements, opinions and data contained in all publications are solely those of the individual author(s) and contributor(s) and not of MDPI and/or the editor(s). MDPI and/or the editor(s) disclaim responsibility for any injury to people or property resulting from any ideas, methods, instructions or products referred to in the content. |
© 2024 by the authors. Licensee MDPI, Basel, Switzerland. This article is an open access article distributed under the terms and conditions of the Creative Commons Attribution (CC BY) license (https://creativecommons.org/licenses/by/4.0/).
Share and Cite
Masi, M.; Nedjar, D.; Bani, M.; Staiano, I.; Salvatore, M.M.; Khenaka, K.; Castaldi, S.; Zorrilla, J.G.; Andolfi, A.; Isticato, R.; et al. An Algerian Soil-Living Streptomyces alboflavus Strain as Source of Antifungal Compounds for the Management of the Pea Pathogen Fusarium oxysporum f. sp. pisi. J. Fungi 2024, 10, 783. https://doi.org/10.3390/jof10110783
Masi M, Nedjar D, Bani M, Staiano I, Salvatore MM, Khenaka K, Castaldi S, Zorrilla JG, Andolfi A, Isticato R, et al. An Algerian Soil-Living Streptomyces alboflavus Strain as Source of Antifungal Compounds for the Management of the Pea Pathogen Fusarium oxysporum f. sp. pisi. Journal of Fungi. 2024; 10(11):783. https://doi.org/10.3390/jof10110783
Chicago/Turabian StyleMasi, Marco, Dorsaf Nedjar, Moustafa Bani, Ivana Staiano, Maria Michela Salvatore, Karima Khenaka, Stefany Castaldi, Jesus Garcia Zorrilla, Anna Andolfi, Rachele Isticato, and et al. 2024. "An Algerian Soil-Living Streptomyces alboflavus Strain as Source of Antifungal Compounds for the Management of the Pea Pathogen Fusarium oxysporum f. sp. pisi" Journal of Fungi 10, no. 11: 783. https://doi.org/10.3390/jof10110783
APA StyleMasi, M., Nedjar, D., Bani, M., Staiano, I., Salvatore, M. M., Khenaka, K., Castaldi, S., Zorrilla, J. G., Andolfi, A., Isticato, R., & Cimmino, A. (2024). An Algerian Soil-Living Streptomyces alboflavus Strain as Source of Antifungal Compounds for the Management of the Pea Pathogen Fusarium oxysporum f. sp. pisi. Journal of Fungi, 10(11), 783. https://doi.org/10.3390/jof10110783

